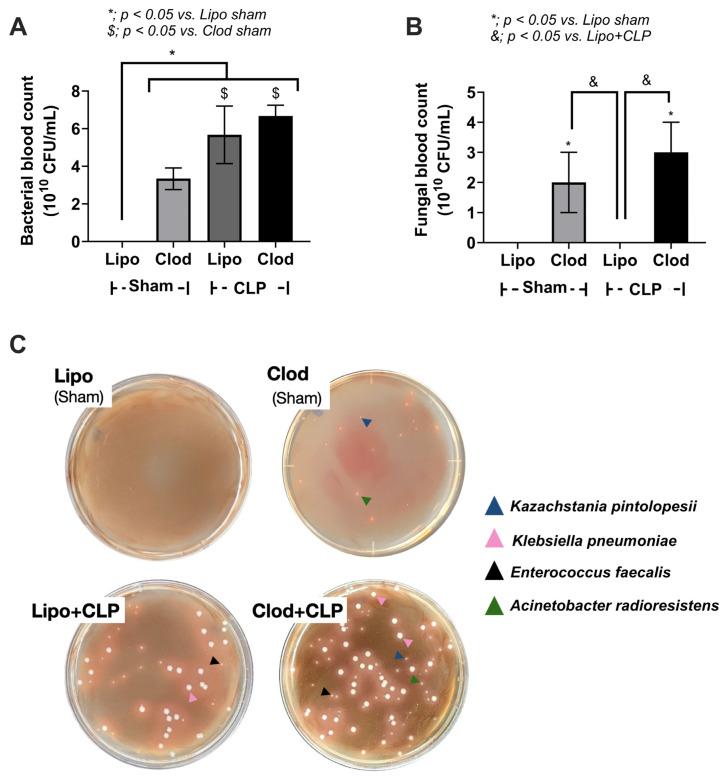
https://cdn.ncbi.nlm.nih.gov/pmc/blobs/2068/10744925/bfd4ddc9be94/jof-09-01164-g005.jpg

在盲肠结扎穿刺致巨噬细胞缺失小鼠的血液和肠壁中,巨噬细胞在脓毒症期间对真菌的控制作用
in Blood and Intestinal Wall of Macrophage-Depleted Mice with Cecal Ligation and Puncture, the Control of Fungi by Macrophages during Sepsis.
作者信息
Hiengrach Pratsanee, Chindamporn Ariya, Leelahavanichkul Asada
机构信息
Department of Microbiology, Faculty of Medicine, Khon Kaen University, Khon Kaen 40002, Thailand.
Research and Diagnostic Center for Emerging Infectious Diseases (RCEID), Faculty of Medicine, Khon Kaen University, Khon Kaen 40002, Thailand.
出版信息
J Fungi (Basel). 2023 Dec 4;9(12):1164. doi: 10.3390/jof9121164.
Although macrophage depletion is a possible emerging therapeutic strategy for osteoporosis and melanoma, the lack of macrophage functions can lead to inappropriate microbial control, especially the regulation of intestinal microbiota. Cecal ligation and puncture (CLP) sepsis was performed in regular mice and in mice with clodronate-induced macrophage depletion. Macrophage depletion significantly increased the mortality and severity of sepsis-CLP mice, partly through the increased fecal Ascomycota, especially , with polymicrobialbacteremia (, , and ). Indeed, macrophage depletion with sepsis facilitated gut dysbiosis that directly affected gut permeability as yeast cells were located and hidden in the colon crypts. To determine the interactions of fungal molecules on bacterial abundance, the heat-kill lysate of fungi ( and ) and purified (1→3)-β-d-glucan (BG; a major component of the fungal cell wall) were incubated with bacteria that were isolated from the blood of macrophage-depleted mice. There was enhanced cytokine production of enterocytes (Caco-2) after the incubation of the lysate of (isolated from sepsis mice), the lysate of (extracted from sepsis patients), and BG, together with bacterial lysate. These data support a possible influence of fungi in worsening sepsis severity. In conclusion, macrophage depletion enhanced in feces, causing the overgrowth of fecal pathogenic bacteria and inducing a gut permeability defect that additively worsened sepsis severity. Hence, the fecal fungus could be spontaneously elevated and altered in response to macrophage-depleted therapy, which might be associated with sepsis severity.
尽管巨噬细胞耗竭可能是一种新兴的骨质疏松症和黑色素瘤治疗策略,但巨噬细胞功能的缺失会导致微生物控制不当,尤其是肠道微生物群的调节。对正常小鼠和经氯膦酸盐诱导巨噬细胞耗竭的小鼠进行盲肠结扎和穿刺(CLP)败血症实验。巨噬细胞耗竭显著增加了CLP败血症小鼠的死亡率和严重程度,部分原因是粪便中子囊菌增加,尤其是在多微生物菌血症(、和)的情况下。事实上,败血症导致的巨噬细胞耗竭促进了肠道生态失调,直接影响肠道通透性,因为酵母细胞位于结肠隐窝并隐藏其中。为了确定真菌分子与细菌丰度之间的相互作用,将真菌(和)的热灭活裂解物以及纯化的(1→3)-β-D-葡聚糖(BG;真菌细胞壁的主要成分)与从巨噬细胞耗竭小鼠血液中分离出的细菌一起孵育。在用(从败血症小鼠中分离)、(从败血症患者中提取)和BG的裂解物与细菌裂解物一起孵育后,肠上皮细胞(Caco-2)的细胞因子产生增加。这些数据支持真菌可能对败血症严重程度恶化有影响。总之,巨噬细胞耗竭增加了粪便中的,导致粪便中致病细菌过度生长,并诱导肠道通透性缺陷,进而加重败血症严重程度。因此,粪便真菌可能会因巨噬细胞耗竭治疗而自发升高并发生改变,这可能与败血症严重程度有关。